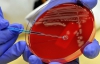

Президент України Віктор Янукович привітав медиків із професійним святом – Днем медичного працівника. Про це повідомляє прес-служба глави держави.
"Щоденна сумлінна робота усіх працівників галузі охорони здоров'я, їх високий професіоналізм та відданість справі – це запорука кращого майбутнього України. Адже здоров'я нації – наше найбільше багатство. Бажаю вам міцного здоров'я, добра та успіхів на благо українського народу", – сказав Президент.
Також він зауважив, що пріоритетним завданням програми реформ визначено докорінну модернізацію медичного обслуговування, мета якої – зробити медицину доступною і якісною для кожної української сім'ї.
" Ключова теза реформи – гідна заробітна плата і соціальні гарантії для медичних працівників. Сподіваюся на ваше розуміння тривалості процесу реформування, адже тільки зростання економіки забезпечить суттєве збільшення фінансування галузі", – йдеться у привітанні Януковича.

Коментарі
2